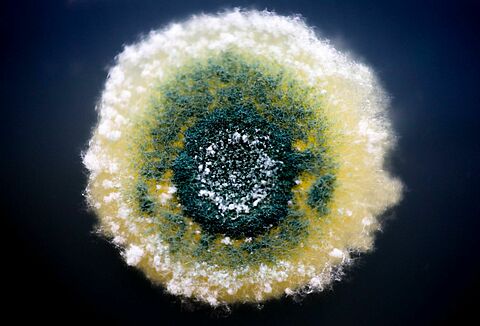
TRIANUM – vairo Jūsu sējeņu un jaunstādu veselību un spēku

- Koppert Global
- Argentina
- Austria
- Belgium
- Brasil
- Canada (English)
- Canada (French)
- Chile
- Ecuador
- Finland (Finnish)
- Finland (Swedish)
- France
- Germany
- Greece
- Hungary
- India
- Italy
- Kenya
- Korea
- Mexico
- Netherlands
- Paraguay
- Peru
- Poland
- Portugal
- Russia
- South Africa
- Spain
- Sweden
- Switzerland
- Turkey
- USA
- United Kingdom
TRIANUM – vairo Jūsu sējeņu un jaunstādu veselību un spēku
August 29, 2024
Need help?
